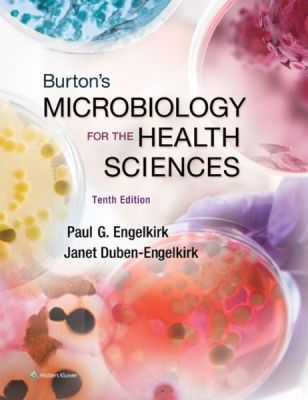

Burton's Microbiology for the Health Sciences, 10th edition, International Edition
by Paul Engelkirk-
Paperback
KWD18.600
Prepare your students for success in their future careers with Burton’s Microbiology for the Health Sciences, 10e. Featuring a clear and friendly writing style that emphasizes the relevance of microbiology to a career in the health professions, the Tenth Edition offers a dramatically updated art program, new case studies that provide a real-life context for the content, the latest information on bacterial pathogens, an unsurpassed array of online teaching and learning resources, and much more.
To ensure content mastery, this market-leading book for the one-semester course clarifies concepts, defines key terms, and is packed with in-text learning tools that make the content inviting and easy to understand. The Tenth Edition provides a wide range of online teaching and learning resources to save you time and help your students succeed.
Instructor Resources:
An Image Bank featuring all figures and tables from the book enhances lecture and exam preparation.
A robust Test Generator, loaded with pre-made, text-specific questions, saves time and makes creating and printing tests easy.
Lesson Plans make teaching from the text easier.
PowerPoint Slides speed lecture preparation.
An Instructor's Guide provides additional resources for every chapter.
Student Resources:
A chapter-by-chapter Study Guide helps students master key concepts.
Additional Self-Assessment Exercises for each chapter help students build confidence and gauge their progress
Lists of Key Terms in each chapter help students master the vocabulary of the field.
Special "Insight," "Increase Your Knowledge," and "Critical thinking" sections provide additional insight, as well as fun facts on selected topics from the text.
Student Quiz Bank – over 500 questions—give students unlimited opportunities for practice and review.